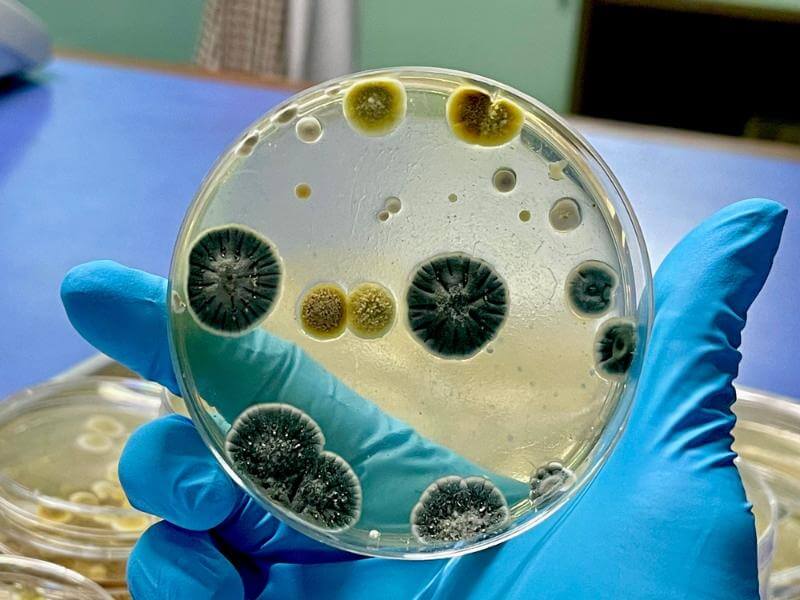

Department of Plant Pathology
Plant Pathology is the scientific discipline concerned with the study of plant diseases, their causal organisms, mechanisms of infection, and strategies for management. In the B.Sc. (Hons.) Agriculture programme, it holds great significance as it imparts knowledge on diagnosing plant health issues and developing sustainable disease management practices. The Department emphasizes experiential learning through visits to different locations for the collection of diseased specimens, followed by laboratory-based identification of beneficial and harmful pathogens. Students are trained in various diagnostic and control techniques, including cultural, biological, and integrated approaches, while also gaining practical experience in culturing beneficial microorganisms that support plant health. This comprehensive training equips students with the scientific understanding and practical competence required to manage crop diseases effectively and contribute to sustainable agricultural production.